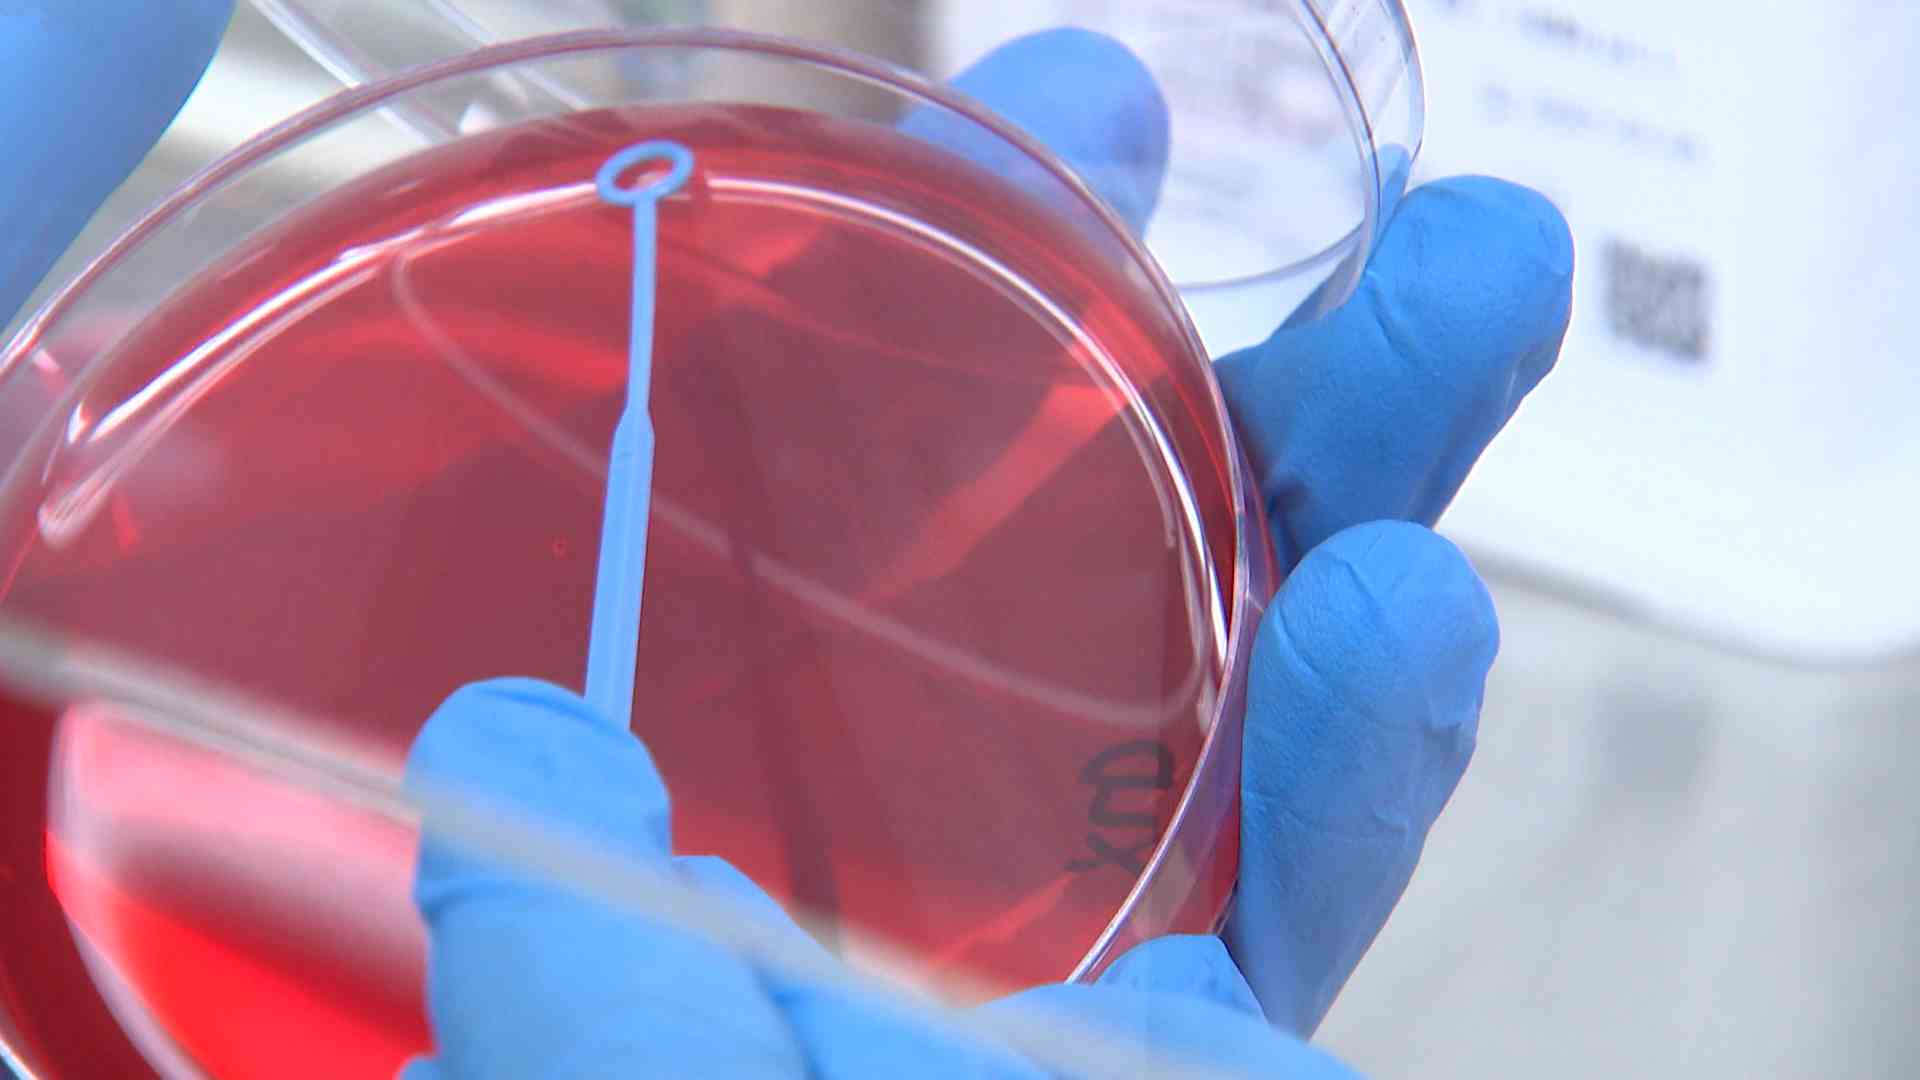

보건당국이 기온이 상승하는 여름철 세균성 식중독 발생에 주의를 당부했습니다.
보건당국이 기온이 상승하는 여름철 세균성 식중독 발생에 주의를 당부했습니다.
울산시 보건환경연구원은 식중독균 증식이 활발한 요즘 생채소와 김치, 달걀, 육류 등을 섭취하거나 보관할 때 세심한 주의를 당부했습니다.
연구원은 시중에 유통되는 비가열 섭취 식품 50건을 수거해 살모넬라와 병원성 대장균 등 18종을 분석하는 등 식중독 예방 활동을 벌이고 있습니다.
Copyright © Ulsan Munhwa Broadcasting Corporation. All rights reserved.

취재기자
choigo@usmbc.co.kr